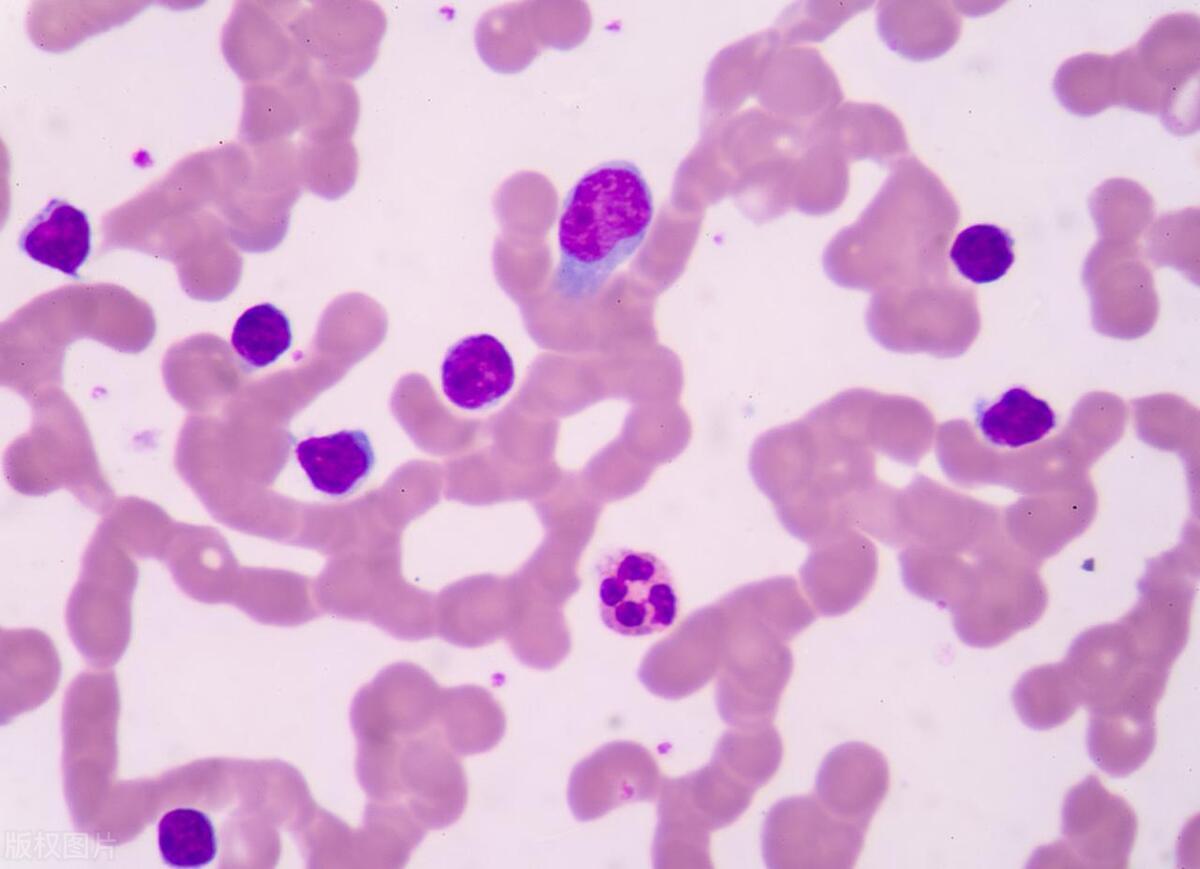

血型決定壽命?A 型、B 型、O 型、AB 型,哪種更容易患癌?
在健康領域,血型與人體健康的關係一直是人們津津樂道的話題。其中,血型是否決定壽命,以及不同血型患癌風險的差異,備受大衆關注。那麼,A 型、B 型、O 型、AB 型血,究竟哪種更容易患癌呢?
血型的基本認知
人類血型主要分爲 A、B、O 和 AB 四種類型 。血型的差異由紅細胞表面的抗原決定,這些抗原不僅影響着輸血的兼容性,還可能在一定程度上與人體的生理和病理過程相關聯。但需要明確的是,血型只是人體衆多生理特徵之一,不能單獨決定一個人的整體健康狀況和壽命長短。

血型與壽命的關係
目前並沒有確鑿的科學證據表明血型能直接決定壽命 。壽命受到多種複雜因素的綜合影響,包括遺傳因素、生活方式(如飲食、運動、吸菸飲酒習慣等)、環境因素(如污染程度、生活壓力等)以及醫療條件等。雖然有一些小規模的研究試圖探討血型與壽命的關聯,但由於樣本量有限、研究方法的侷限性等,這些研究結果並不具有廣泛的代表性和說服力。

血型與患癌風險的研究
1、A 型血:部分研究顯示,A 型血的人可能在某些癌症的發病風險上略有升高。例如,有研究表明 A 型血人羣患胃癌、胰腺癌的風險相對較高。這可能與 A 型血人羣的某些生理特性有關,比如 A 型血的人血液黏稠度相對較高,可能影響血液循環,進而影響身體的免疫功能和細胞的新陳代謝,使得癌細胞更容易生長和發展。但這並不意味着 A 型血的人必然會患這些癌症,只是相對風險有所增加。
2、B 型血:關於 B 型血與癌症的關係,研究結果相對複雜。一些研究提示,B 型血的人在某些消化系統癌症,如結直腸癌方面,可能存在一定的發病風險差異。不過,這種差異並不顯著,而且不同地區、不同人羣的研究結果也存在一定的分歧。總體而言,B 型血與癌症的關聯還需要更多大規模、深入的研究來明確。
3、O 型血:在一些研究中,O 型血被認爲具有一定的優勢。有觀點稱 O 型血的人患血栓性疾病的風險相對較低,而良好的血液循環可能有助於身體及時清除體內的有害物質和癌細胞。然而,也有研究指出,O 型血的人在患某些癌症,如膀胱癌方面,可能存在一定的風險。但這些研究結果同樣需要進一步驗證。
4、AB 型血:AB 型血是相對較爲特殊的血型,它兼具 A、B 型血的特點。有研究表明,AB 型血的人在心血管疾病方面可能面臨更高的風險,而心血管疾病與癌症之間可能存在一定的潛在聯繫。但目前關於 AB 型血與癌症直接關聯的研究相對較少,結論也不夠明確。

雖然有一些研究探索了血型與癌症之間的關係,但目前並沒有足夠的證據能夠確切地表明哪種血型更容易患癌。癌症的發生是一個多因素共同作用的過程,包括遺傳易感性、不良生活習慣(如長期吸菸、酗酒、不健康飲食等)、環境污染、病毒感染等。保持健康的生活方式,如均衡飲食、適量運動、戒菸限酒、定期體檢等,對於降低患癌風險和保持身體健康至關重要,而不應過度糾結於血型因素。

















